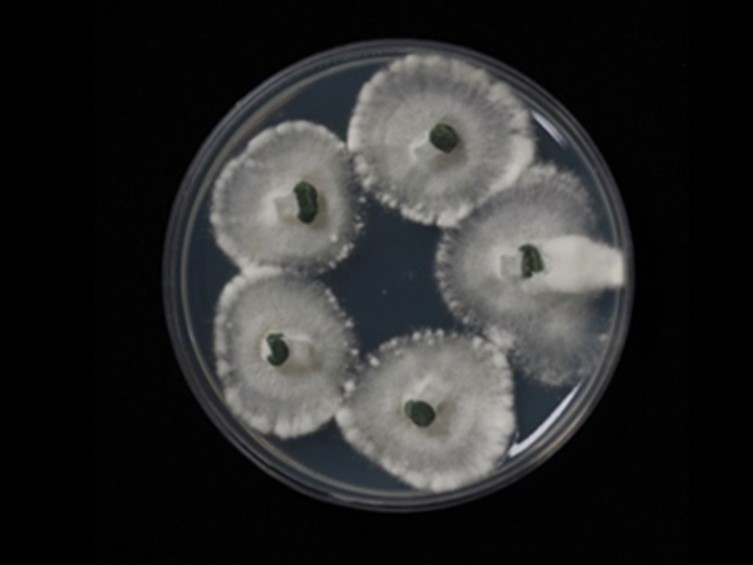

Holotype:
THAILAND, Tak Province, Umphang Wildlife Sanctuary, 4 Sep. 2016, J.J. Luangsa-ard, K. Tasanathai, S. Mongkolsamrit, P. Srikittikulchai, A. Khonsanit, B. Thongnuch, holotype BBH 25192, ex-type living culture BCC 30939.
Habitat:
Buried in the ground.
Host:
Cicada nymph (Hemiptera).
Description:
 Stromata simple, cylindrical, greyish green to almost dark green arising from the head of the cicada nymphs, 70-130 × 0.6-1.8 mm. Terminal part of the stroma fertile, cylindrical.
Stromata simple, cylindrical, greyish green to almost dark green arising from the head of the cicada nymphs, 70-130 × 0.6-1.8 mm. Terminal part of the stroma fertile, cylindrical.  Perithecia flask-shaped, oblique in arrangement, 510-550 × 250-350 μm.
Perithecia flask-shaped, oblique in arrangement, 510-550 × 250-350 μm.  Asci hyaline, cylindrical, 275-400 × 5 μm.
Asci hyaline, cylindrical, 275-400 × 5 μm.  Ascospores filiform, hyaline, not fragmenting into part-spores, 155-230 × 1.25 μm.
Ascospores filiform, hyaline, not fragmenting into part-spores, 155-230 × 1.25 μm.
Culture characteristics:
Colonies on PDA attaining a diam of 10 mm in 10 d, at first white turning greenish olive due to the production of conidia in the middle of colony. Phialides fusiform to narrowly ovoid, 3–5 × 2 μm. Conidia catenulate, dimorphic; microconidia formed first, ovoid, ellipsoidal or subglobose, 3–5 × 2–3 μm, macroconidia formed later, cylindrical, clavate, 8–16 × 3–4 μm.
Colonies on PDA attaining a diam of 10 mm in 10 d, at first white turning greenish olive due to the production of conidia in the middle of colony. Phialides fusiform to narrowly ovoid, 3–5 × 2 μm. Conidia catenulate, dimorphic; microconidia formed first, ovoid, ellipsoidal or subglobose, 3–5 × 2–3 μm, macroconidia formed later, cylindrical, clavate, 8–16 × 3–4 μm.
Reference:
Mongkolsamrit S, Khonsanit A, Thanakitpipattana D, et al. (2020). Revisiting Metarhizium and the description of new species from Thailand. Studies in Mycology 95: 171–251.
DOI: https://doi.org/10.1016/j.simyco.2020.04.001Species |
Strain |
Compound |
Pubchem CID |
Biological activity |
Reference |
|---|
|
Strain |
ITS | LSU | RPB1 | RPB2 | SSU |
|---|---|---|---|---|---|
| BCC 30934 | HQ165698 | HQ165720 | HQ165740 | HQ165639 | HQ165658 |
| BCC 30939 | HQ165699 | HQ165721 | HQ165741 | HQ165640 | HQ165659 |